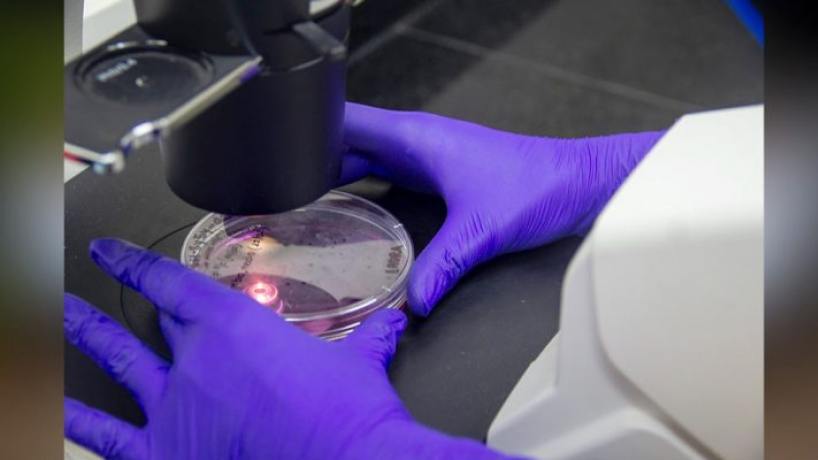

Ciencia tucumana: la investigadora Rosana Cheín impulsa avances contra el Parkinson y alienta a las niñas a seguir carreras científicas
La directora del Instituto de Investigaciones en Medicina Molecular y Celular Aplicada (IMMCA), lidera en Tucumán investigaciones que buscan avanzar en el diagnóstico y tratamiento de enfermedades neurodegenerativas como el Parkinson y el Alzheimer.
La investigadora del CONICET y docente de la Universidad Nacional de Tucumán (UNT), Cheín recordó con MEDIOS UNT que su vocación científica nació en la infancia, en la reciente entrevista que le realizaron por el Día de la Mujer y la Niña en la ciencia. “De chiquita quería ser científica. Mi mamá me compraba todos los libros de Julio Verne y crecí con él”, contó al recordar cómo surgió su interés por la investigación biomédica.
Hoy dirige el IMMCA, un instituto de triple dependencia entre la UNT, el CONICET y el Sistema Provincial de Salud (SIPROSA), desde donde coordina distintos proyectos científicos enfocados principalmente en enfermedades neurodegenerativas.
En ese camino, su equipo logró un hallazgo que podría tener impacto internacional: el desarrollo de una nueva molécula con potencial terapéutico para el Parkinson.
Según explicó la investigadora, se trata de un compuesto innovador que no solo podría aliviar los síntomas de la enfermedad, sino también proteger las neuronas afectadas. “Encontramos una nueva molécula, única en su tipo en el mercado para el Parkinson, que además de aliviar los síntomas tiene funciones neuroprotectoras”, señaló. La patente ya fue aceptada en varios países, incluido Estados Unidos, y actualmente se encuentra en proceso de evaluación como posible candidato a fármaco.
Este desarrollo se suma a otros proyectos del instituto vinculados al diagnóstico temprano del Parkinson. En junio pasado, Cheín presentó avances en la validación de un test de alta sensibilidad que permitiría detectar la enfermedad en etapas iniciales, incluso años antes de la aparición de los síntomas clínicos.
Actualmente, el diagnóstico del Parkinson suele realizarse cuando aparecen signos motores o deterioro cognitivo, aunque la enfermedad puede haber comenzado una década antes. Por eso, contar con herramientas de detección temprana podría permitir intervenir antes y mejorar la eficacia de los tratamientos.
En distintas instancias de divulgación científica —como las actividades realizadas en torno al Día Internacional de la Mujer y la Niña en la Ciencia— Cheín también suele reflexionar sobre el rol de las mujeres en la investigación y alentar a las nuevas generaciones a seguir ese camino.
“Rescatando a esa niña que fui, quiero decirles a todas las mujeres y a todas las niñas que sueñan con ser heroínas haciendo ciencia que se puede. Es fascinante”, expresó.
La científica recordó además el caso de la investigadora británica Rosalind Franklin, clave para el descubrimiento de la estructura del ADN pero durante años invisibilizada en la historia de la ciencia. “Siempre les cuento a mis alumnos su historia. Gracias a ella se descubrió la estructura del ADN y jamás fue reconocida. Hoy en día eso no pasaría, pero como mujeres tenemos que seguir sosteniendo para que eso nunca vuelva a suceder”, afirmó.
Con investigaciones que van desde el diagnóstico temprano hasta el desarrollo de nuevas terapias, el trabajo del IMMCA posiciona a Tucumán como un centro relevante en el estudio de enfermedades neurodegenerativas, mientras la trayectoria de Cheín se convierte en un ejemplo para futuras generaciones de científicas.
